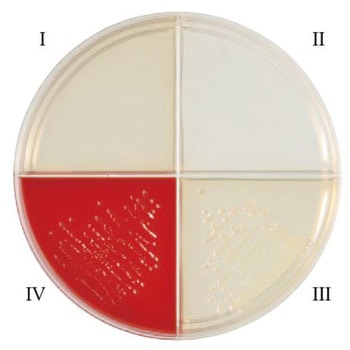
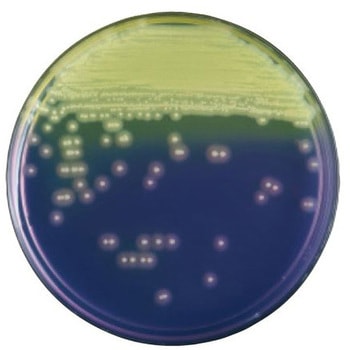

絞り込み
ブランド
- Merck(メルクミリポア)(476)
- ベクトン・ディッキンソン(369)
- 栄研化学(44)
- 島津ダイアグノスティクス(30)
- 極東製薬工業(20)
- アズワン(13)
- キッコーマンバイオケミファ(9)
- エルメックス(6)
- Solventum(ソルベンタム)(旧スリーエム ヘルスケア)(5)
- ADVANTEC(3)
- ケニス(3)
- VWR(3)
- TGK(東京硝子器械)(2)
- サン化学(2)
- PALL(ポール)(2)
- 関東化学(2)
- 林純薬工業(2)
- シグマアルドリッチ(2)
- 伊那食品工業(2)
- ブランドをもっと見る
12ページ目: 培地
「種類」から絞り込む
 BD Difco TM MUG添加ニュートリエント寒天培地ベクトン・ディッキンソン
BD Difco TM MUG添加ニュートリエント寒天培地ベクトン・ディッキンソン¥55,980税込¥61,578
1個
31日以内出荷
水中の大腸菌の検出および菌数測定を発光酵素基質法で検出します。
質量(g)500タイプ一般細菌用種類寒天培地アズワン品番63-6527-97
 BD BBL TM PEA添加アネロコロンビアRS血液寒天培地/BBE寒天培地 10枚ベクトン・ディッキンソン
BD BBL TM PEA添加アネロコロンビアRS血液寒天培地/BBE寒天培地 10枚ベクトン・ディッキンソン¥6,498税込¥7,148
1個(10枚×1本)
6日以内出荷
BDの新嫌気性菌用培地『アネロコロンビアRS血液寒天培地』に、フェニルエチルアルコールを添加し、大腸菌やプロテウスなどのグラム陰性菌の発育を阻止し、グラム陽性菌の選択に適した血液寒天培地です
種類寒天培地アズワン品番63-6527-94保管環境冷蔵
 BD BBL TM サルモネラ・シゲラ寒天培地/TCBS寒天培地 100枚ベクトン・ディッキンソン
BD BBL TM サルモネラ・シゲラ寒天培地/TCBS寒天培地 100枚ベクトン・ディッキンソン¥31,980税込¥35,178
1個(100枚×1本)
6日以内出荷
本培地は1枚で2種類の培地が併用できる様に組み合わされた便利で効率の良い培地で、糞便検体からSalmonella、Shigellaの分離培養に適したサルモネラ・シゲラ寒天培地とV. cholerae およびV. parahaemolyticus等の病原性Vibrioの分離培養に適したTCBS寒天培地との組み合わせです
種類寒天培地アズワン品番63-6527-93保管環境冷蔵
 BD BBL TM 白糖加サルモネラ・シゲラ寒天培地/ CT-ソルビトール添加マッコンキーⅡ寒天培地 100枚ベクトン・ディッキンソン
BD BBL TM 白糖加サルモネラ・シゲラ寒天培地/ CT-ソルビトール添加マッコンキーⅡ寒天培地 100枚ベクトン・ディッキンソン¥12,500税込¥13,750
1個(100枚×1本)
6日以内出荷
本培地は1枚で2種類の培地が併用できる様に組み合わされた便利で効率の良い培地で、糞便検体からSalmonella、Shigella の分離培養に適した白糖加SS 寒天培地と病原性大腸菌O157 の分離培養に適したCT- ソルビトール添加マッコンキーII 寒天培地との組み合わせです
種類寒天培地アズワン品番63-6527-92保管環境冷蔵
 BD BBL TM 変法サルモネラ・シゲラ寒天培地/CT-ソルビトール添加マッコンキーⅡ寒天培地 LDIP 100枚ベクトン・ディッキンソン
BD BBL TM 変法サルモネラ・シゲラ寒天培地/CT-ソルビトール添加マッコンキーⅡ寒天培地 LDIP 100枚ベクトン・ディッキンソン¥22,980税込¥25,278
1個(100枚×1本)
6日以内出荷
本培地は1枚で2種類の培地が併用できる様に組み合わされた便利で効率の良い培地で、糞便検体からSalmonella、Shigella の分離培養に適した変法サルモネラシゲラ寒天培地と病原性大腸菌O157 の分離培養に適したCT- ソルビトール添加マッコンキーII 寒天培地との組み合わせです
種類寒天培地アズワン品番63-6527-91保管環境冷蔵
 BD BBL TM サルモネラ・シゲラ寒天培地/ CT-ソルビトール添加マッコンキーⅡ寒天培地 100枚ベクトン・ディッキンソン
BD BBL TM サルモネラ・シゲラ寒天培地/ CT-ソルビトール添加マッコンキーⅡ寒天培地 100枚ベクトン・ディッキンソン¥22,980税込¥25,278
1個(100枚×1本)
6日以内出荷
本培地は1枚で2種類の培地が併用できる様に組み合わされた便利で効率の良い培地で、糞便検体からSalmonella、Shigella の分離培養に適したサルモネラ・シゲラ寒天培地と病原性大腸菌O157 の分離培養に適したCT- ソルビトール添加マッコンキーII 寒天培地との組み合わせです
種類寒天培地アズワン品番63-6527-90保管環境冷蔵
 BD BBL TM TSAⅡ5%ヒツジ血液寒天培地/CHROMagar TM オリエンテーション寒天培地 100枚ベクトン・ディッキンソン
BD BBL TM TSAⅡ5%ヒツジ血液寒天培地/CHROMagar TM オリエンテーション寒天培地 100枚ベクトン・ディッキンソン¥14,980税込¥16,478
1個(100枚×1本)
6日以内出荷
本培地は1枚で2種類の培地が併用できる様に組み合わされた便利で効率の良い培地で、発育性、溶血反応にすぐれた一般分離用TSA II5%ヒツジ血液寒天培地と尿検体から起因菌の分離・菌数測定用に用いる非選択培地である、CHROMagar(TM) オリエンテーション寒天培地の組み合わせです
種類寒天培地アズワン品番63-6527-88保管環境冷蔵
 BD BBL TM TSAⅡ5%ヒツジ血液寒天培地/DHL寒天培地 100枚ベクトン・ディッキンソン
BD BBL TM TSAⅡ5%ヒツジ血液寒天培地/DHL寒天培地 100枚ベクトン・ディッキンソン¥12,980税込¥14,278
1個(100枚×1本)
6日以内出荷
本培地は、1枚で2種類の培地が併用できる様に組合わされた便利で効率の良い培地で、発育性、溶血反応にすぐれた一般分離用TSA II5%ヒツジ血液寒天培地と、グラム陰性桿菌の選択分離にすぐれたDHL 寒天培地の組合わせです
種類寒天培地アズワン品番63-6527-87保管環境冷蔵
 BD BBL TM CA添加5%ヒツジ血液寒天培地/マッコンキーⅡ寒天培地LDIP 20枚ベクトン・ディッキンソン
BD BBL TM CA添加5%ヒツジ血液寒天培地/マッコンキーⅡ寒天培地LDIP 20枚ベクトン・ディッキンソン¥6,498税込¥7,148
1個(20枚×1本)
6日以内出荷
ヒツジ血液寒天培地(M)にコリスチンとアズトレオナムを添加し、グラム陽性菌の選択に適した血液寒天培地と、グラム陰性桿菌の選択分離培地であるマッコンキーII寒天培地の組み合わせです。
種類寒天培地アズワン品番63-6527-85保管環境冷蔵
 BD BBL TM TSAⅡ5%ヒツジ血液寒天培地/マッコンキーⅡ寒天培地 20枚ベクトン・ディッキンソン
BD BBL TM TSAⅡ5%ヒツジ血液寒天培地/マッコンキーⅡ寒天培地 20枚ベクトン・ディッキンソン¥5,698税込¥6,268
1個(20枚×1本)
6日以内出荷
本培地は、1枚で2種類の培地が併用できる様に組合わされた便利で効率の良い培地で、発育性、溶血反応にすぐれた一般分離用TSA II5%ヒツジ血液寒天培地と、グラム陰性桿菌の選択分離にすぐれたマッコンキーII 寒天培地の組合わせです
種類寒天培地アズワン品番63-6527-84保管環境冷蔵
 BD BBL TM TSAⅡ5%ヒツジ血液寒天培地/バシトラシン添加チョコレートⅡ寒天培地 20枚ベクトン・ディッキンソン
BD BBL TM TSAⅡ5%ヒツジ血液寒天培地/バシトラシン添加チョコレートⅡ寒天培地 20枚ベクトン・ディッキンソン¥6,498税込¥7,148
1個(20枚×1本)
6日以内出荷
本培地は、1枚で2種類の培地が併用できる様に組み合わされた便利で効率の良い培地で、発育性、溶血反応にすぐれた一般分離用TSA II5%ヒツジ血液寒天培地と、Haemophilus を選択的に分離できるバシトラシン添加チョコレートII 寒天培地との組み合わせです
種類寒天培地アズワン品番63-6527-83保管環境冷蔵
 BD BBL TM TSAⅡ5%ヒツジ血液寒天培地/チョコレートⅡ寒天培地ベクトン・ディッキンソン
BD BBL TM TSAⅡ5%ヒツジ血液寒天培地/チョコレートⅡ寒天培地ベクトン・ディッキンソン¥6,998~税込¥7,698~
1個(20枚×1本)ほか
6日以内出荷
本培地は、1枚で2種類の培地が併用できる様に組合わされた便利で効率の良い培地で、発育性、溶血反応にすぐれた一般分離用のTSAII5%ヒツジ血液寒天培地とHaemophilus、Neisseria などの栄養要求の厳しい菌の分離培養に最適なチョコレートII 寒天培地の組合わせです
種類寒天培地保管環境冷蔵
 BD BBL TM 7H11寒天培地 20枚ベクトン・ディッキンソン
BD BBL TM 7H11寒天培地 20枚ベクトン・ディッキンソン¥7,798税込¥8,578
1個(20枚×1本)
6日以内出荷
7H11 寒天培地は抗酸性菌、特にMycobacterium tuberculosis(結核菌) を臨床および非臨床検体からの分離および培養に用いられます
タイプ抗酸菌用種類寒天培地アズワン品番63-6527-75保管環境冷蔵
 BD BBL TM コロンビアHP寒天培地ベクトン・ディッキンソン
BD BBL TM コロンビアHP寒天培地ベクトン・ディッキンソン¥7,798税込¥8,578
1個(20枚×1本)
6日以内出荷
コロンビアHP寒天培地は胃粘膜等の検体からH. pylori (以下H. pylori)を効率良く分離することを目的として開発された培地です
タイプヘリコバクター用種類寒天培地保管環境冷蔵
BD BBL TM ヘモフィルスID4分画培地 10枚ベクトン・ディッキンソン
BD BBL TM ヘモフィルスID4分画培地 10枚ベクトン・ディッキンソン¥5,798税込¥6,378
1個(10枚×1本)
6日以内出荷
ヘモフィルスID4 分画は発育因子を添加したブレインハートインフュージョンの4 分画平板で、X 因子、V 因子の要求性及び溶血反応でヘモフィルス属の区別に用います
タイプヘモフィルス用アズワン品番63-6527-71保管環境冷蔵
 BD BBL TM バシトラシン添加チョコレートⅡ寒天培地 20枚ベクトン・ディッキンソン
BD BBL TM バシトラシン添加チョコレートⅡ寒天培地 20枚ベクトン・ディッキンソン¥8,098税込¥8,908
1個(20枚×1本)
6日以内出荷
バシトラシン添加チョコレートII 寒天培地は、チョコレートII 寒天培地〔GCII 寒天培地を基礎としてヘモグロビンとエンリッチメント(アイソバイタルX)を加えた培地〕にバシトラシンを添加した培地で、常在菌が存在する上気道の検体からHaemophilus を選択的に分離し、すぐれた発育を期待することができます
タイプヘモフィルス用種類寒天培地アズワン品番63-6527-70保管環境冷蔵
 BD BBL TM CHROMagar TM O157寒天培地ベクトン・ディッキンソン
BD BBL TM CHROMagar TM O157寒天培地ベクトン・ディッキンソン¥5,998~税込¥6,598~
1個(20枚×1本)ほか
6日以内出荷
BD CHROMagar(TM) O157寒天培地は、臨床材料・保菌者検査材料および食品検査材料などからE. coli O157:H7を検出するための新しい選択分離培地です
タイプO157用種類寒天培地保管環境冷蔵
 BD BBL TM CHROMagar TM サルモネラ寒天培地 100枚ベクトン・ディッキンソン
BD BBL TM CHROMagar TM サルモネラ寒天培地 100枚ベクトン・ディッキンソン¥29,980税込¥32,978
1個(100枚×1本)
8日以内出荷
CHROMagar(TM) サルモネラ寒天培地は、臨床材料・保菌者検査材料および食品検査材料などからサルモネラ菌を検出するための新しい選択分離培地です
タイプサルモネラ用種類寒天培地アズワン品番63-6527-67保管環境冷蔵
 BD BBL TM CLED寒天培地ベクトン・ディッキンソン
BD BBL TM CLED寒天培地ベクトン・ディッキンソン¥5,198~税込¥5,718~
1個(20枚×1本)ほか
6日以内出荷
CLED寒天培地は、尿中細菌の定量と分離培養に適しており、尿路感染症を診断するのに推奨されます
タイプ尿中細菌用種類寒天培地保管環境冷蔵
 BD BBL TM CHROMagar TM オリエンテーション寒天培地ベクトン・ディッキンソン
BD BBL TM CHROMagar TM オリエンテーション寒天培地ベクトン・ディッキンソン¥5,998~税込¥6,598~
1個(20枚×1本)ほか
6日以内出荷
尿検体から起因菌の分離および菌数測定用に用いる非選択培地です
タイプ尿中細菌用種類寒天培地保管環境冷蔵
 BD BBL TM CIN寒天培地 20枚ベクトン・ディッキンソン
BD BBL TM CIN寒天培地 20枚ベクトン・ディッキンソン¥5,198税込¥5,718
1個(20枚×1本)
6日以内出荷
CIN 寒天培地は、検査材料からのYersinia の選択分離培地です。Y. enterocolitica は24~48時間培養で本培地上に平滑、赤色、湿潤でやや膨隆、コロニーの周辺が白色をおびた特徴あるコロニーを形成します
タイプエルシニア用種類寒天培地アズワン品番63-6527-62保管環境冷蔵
 BD BBL TM TCBS寒天培地ベクトン・ディッキンソン
BD BBL TM TCBS寒天培地ベクトン・ディッキンソン¥9,098~税込¥10,008~
1個(20枚×1本)ほか
6日以内出荷
TCBS寒天培地は、V. choleraeおよびV. parahaemolyticus等の病原性Vibrioの選択的分離に最適です
タイプビブリオ用種類寒天培地保管環境冷蔵
 BD BBL TM スキロー培地 20枚ベクトン・ディッキンソン
BD BBL TM スキロー培地 20枚ベクトン・ディッキンソン¥9,898税込¥10,888
1個(20枚×1本)
4日以内出荷
スキロー培地は、Campylobacter特にC. jejiuniを糞便検体から選択分離するのに適した培地です
タイプカンピロバクター用アズワン品番63-6527-58保管環境冷蔵
 BD BBL TM 変法キャンピロバクター 10%ヒツジ血液寒天培地 H 20枚ベクトン・ディッキンソン
BD BBL TM 変法キャンピロバクター 10%ヒツジ血液寒天培地 H 20枚ベクトン・ディッキンソン¥9,898税込¥10,888
1個(20枚×1本)
6日以内出荷
本培地はヒト糞便検体からC. jejuniの初代分離培養を目的とした選択培地です。C. jejuniは急性腸炎の原因細菌の中では最も一般的に知られています
タイプカンピロバクター用種類寒天培地アズワン品番63-6527-57保管環境冷蔵
 BD BBL TM キャンピロバクター 10%ヒツジ血液寒天培地 20枚ベクトン・ディッキンソン
BD BBL TM キャンピロバクター 10%ヒツジ血液寒天培地 20枚ベクトン・ディッキンソン¥9,898税込¥10,888
1個(20枚×1本)
6日以内出荷
本培地は、Campylobacter特にC. jejuniを糞便検体から選択分離するのに適した培地です
タイプカンピロバクター用種類寒天培地アズワン品番63-6527-56保管環境冷蔵
 BD BBL TM セアーマーチン寒天培地ベクトン・ディッキンソン
BD BBL TM セアーマーチン寒天培地ベクトン・ディッキンソン¥5,698~税込¥6,268~
1個(20枚×1本)ほか
4日以内出荷から6日以内出荷
セアーマーチン寒天培地は、チョコレートII寒天培地にV.C.N.選択剤を添加したもので、咽喉、膣、直腸、尿道などの多種の菌が混在する検査材料からN. gonorrhoeae、N. meningitidisが選択的に分離できます
タイプナイセリア用種類寒天培地保管環境冷蔵
 BD BBL TM サブローデキストロース寒天培地 20枚ベクトン・ディッキンソン
BD BBL TM サブローデキストロース寒天培地 20枚ベクトン・ディッキンソン¥5,498税込¥6,048
1個(20枚×1本)
8日以内出荷
サブローデキストロース寒天培地は、さまざまな検査材料から病原性あるいは、非病原性の真菌を分離・培養するのに適しています
タイプ真菌、イースト、カビ用種類寒天培地アズワン品番63-6527-48保管環境冷蔵
 BD BBL TM VRE選択培地ベクトン・ディッキンソン
BD BBL TM VRE選択培地ベクトン・ディッキンソン¥9,398~税込¥10,338~
1個(20枚×1本)ほか
6日以内出荷から15日以内出荷
VRE 選択培地は、VanA・VanB 選択剤により、特に臨床的に問題となるVanA 型、VanB 型耐性遺伝子を持つVRE を選択する培地です
タイプVRE用保管環境冷蔵
BD BBL TM MRSA選択培地ベクトン・ディッキンソン
BD BBL TM MRSA選択培地ベクトン・ディッキンソン¥6,198~税込¥6,818~
1個(20枚×1本)ほか
6日以内出荷から8日以内出荷
BD MRSA選択培地は、臨床材料からの効率的なMRSA分離を目的とした初代分離培地です
タイプMRSA用保管環境冷蔵
 BD BBL TM GCⅡ寒天培地 20枚ベクトン・ディッキンソン
BD BBL TM GCⅡ寒天培地 20枚ベクトン・ディッキンソン¥5,698税込¥6,268
1個(20枚×1本)
6日以内出荷
本培地は、GCII寒天培地に1%のサプリメント(アイソバイタルエックスエンリッチメント)を添加したものでNeisseria gonorrhoeaeの薬剤感受性試験用として使用できます
タイプ薬剤感受性テスト用種類寒天培地アズワン品番63-6527-40保管環境冷蔵
 BD BBL TM ミューラーヒントン5%ヒツジ血液寒天培地ベクトン・ディッキンソン
BD BBL TM ミューラーヒントン5%ヒツジ血液寒天培地ベクトン・ディッキンソン¥9,398~税込¥10,338~
1個(20枚×1本)ほか
4日以内出荷から6日以内出荷
ミューラーヒントン5%ヒツジ血液寒天培地は、ミューラーヒントンII寒天培地に脱線維ヒツジ血液を添加したもので、通常のミューラーヒントンII寒天培地では満足な発育を示さないStreptococcusなどの細菌の薬剤感受性テストに適しています
タイプ薬剤感受性テスト用種類寒天培地保管環境冷蔵
 BD BBL TM ミューラーヒントンⅡ寒天培地ベクトン・ディッキンソン
BD BBL TM ミューラーヒントンⅡ寒天培地ベクトン・ディッキンソン¥5,498~税込¥6,048~
1個(20枚×1本)ほか
6日以内出荷から8日以内出荷
ミューラーヒントンII 寒天培地は、Kirby-Bauer 法に基く薬剤感受性テスト用培地で、CLSI M2-A9 により推奨されています
タイプ薬剤感受性テスト用種類寒天培地保管環境冷蔵
 BD BBL TM CCFA培地 10枚ベクトン・ディッキンソン
BD BBL TM CCFA培地 10枚ベクトン・ディッキンソン¥4,498税込¥4,948
1個(10枚×1本)
6日以内出荷
CCFA培地は、多種の菌が混在する糞便検体からC. difficileを選択分離する培地です
タイプ嫌気性菌用アズワン品番63-6527-31保管環境冷蔵
 BD BBL TM BBE寒天培地 10枚ベクトン・ディッキンソン
BD BBL TM BBE寒天培地 10枚ベクトン・ディッキンソン¥5,198税込¥5,718
1個(10枚×1本)
4日以内出荷
BBE 寒天培地は、B. fragilis groupの選択分離に用いられます。ゲンタマイシンとウシ胆汁により、通性嫌気性菌と多くのグラム陰性嫌気性菌は選択的に発育が阻止されます
タイプ嫌気性菌用種類寒天培地アズワン品番63-6527-30保管環境冷蔵
 BD BBL TM 変法CDC嫌気性菌用ヒツジ血液寒天培地 10枚ベクトン・ディッキンソン
BD BBL TM 変法CDC嫌気性菌用ヒツジ血液寒天培地 10枚ベクトン・ディッキンソン¥4,898税込¥5,388
1個(10枚×1本)
11日以内出荷
変法CDC 嫌気性菌用ヒツジ血液寒天培地は、従来のCDC 嫌気性菌用ヒツジ血液寒天培地に添加されている血液に工夫を加えることによって、P.melaninogenica group の黒色化を見ることができるように改良したものです
タイプ嫌気性菌用種類寒天培地アズワン品番63-6527-29保管環境冷蔵
 BD BBL TM CDC嫌気性菌用5%ヒツジ血液寒天培地 20枚ベクトン・ディッキンソン
BD BBL TM CDC嫌気性菌用5%ヒツジ血液寒天培地 20枚ベクトン・ディッキンソン¥8,598税込¥9,458
1個(20枚×1本)
6日以内出荷
CDC 嫌気性菌用ヒツジ血液寒天培地は、CDC(Center for DiseaseControl)によって開発された、偏性嫌気性菌の分離、培養の非選択培地です
タイプ嫌気性菌用種類寒天培地アズワン品番63-6527-28保管環境冷蔵
 BD BBL TM PEA添加アネロコロンビアRS血液寒天培地 10枚ベクトン・ディッキンソン
BD BBL TM PEA添加アネロコロンビアRS血液寒天培地 10枚ベクトン・ディッキンソン¥5,798税込¥6,378
1個(10枚×1本)
6日以内出荷
アネロコロンビアRS血液寒天培地に、PEA(フェニルエチルアルコール)を添加し、プロテウスやその他の腸内細菌などが混在する検査材料から、嫌気性菌全般を選択分離するのに適しています
タイプ嫌気性菌用種類寒天培地アズワン品番63-6527-27保管環境冷蔵
 フェニルエチルアルコール 5%羊血液寒培地 20枚ベクトン・ディッキンソン
フェニルエチルアルコール 5%羊血液寒培地 20枚ベクトン・ディッキンソン¥6,198税込¥6,818
1個(20枚×1本)
4日以内出荷
フェニルエチルアルコール5% ヒツジ血液寒天培地は、Streptococcus やStaphylococcus などのグラム陽性球菌の選択的分離に用いられます
タイプグラム陽性球菌用アズワン品番63-6527-22保管環境冷蔵
 BD BBL TM コロンビアCNA5%ヒツジ血液寒天培地 20枚ベクトン・ディッキンソン
BD BBL TM コロンビアCNA5%ヒツジ血液寒天培地 20枚ベクトン・ディッキンソン¥6,498税込¥7,148
1個(20枚×1本)
61日以内出荷
コロンビアCNA 5%ヒツジ血液寒天培地は、様々な菌が混在する検査材料から、グラム陽性球菌の選択的分離に用いるのに適しています
タイプグラム陽性球菌用種類寒天培地アズワン品番63-6527-21保管環境冷蔵
 BD BBL TM CA添加5%ヒツジ血液寒天培地 M 20枚ベクトン・ディッキンソン
BD BBL TM CA添加5%ヒツジ血液寒天培地 M 20枚ベクトン・ディッキンソン¥6,498税込¥7,148
1個(20枚×1本)
6日以内出荷
ヒツジ血液寒天培地(M)にコリスチンとアズトレオナムを添加しているため、グラム陽性菌の選択に適した培地です
タイプグラム陽性球菌用種類寒天培地アズワン品番63-6527-20保管環境冷蔵

















